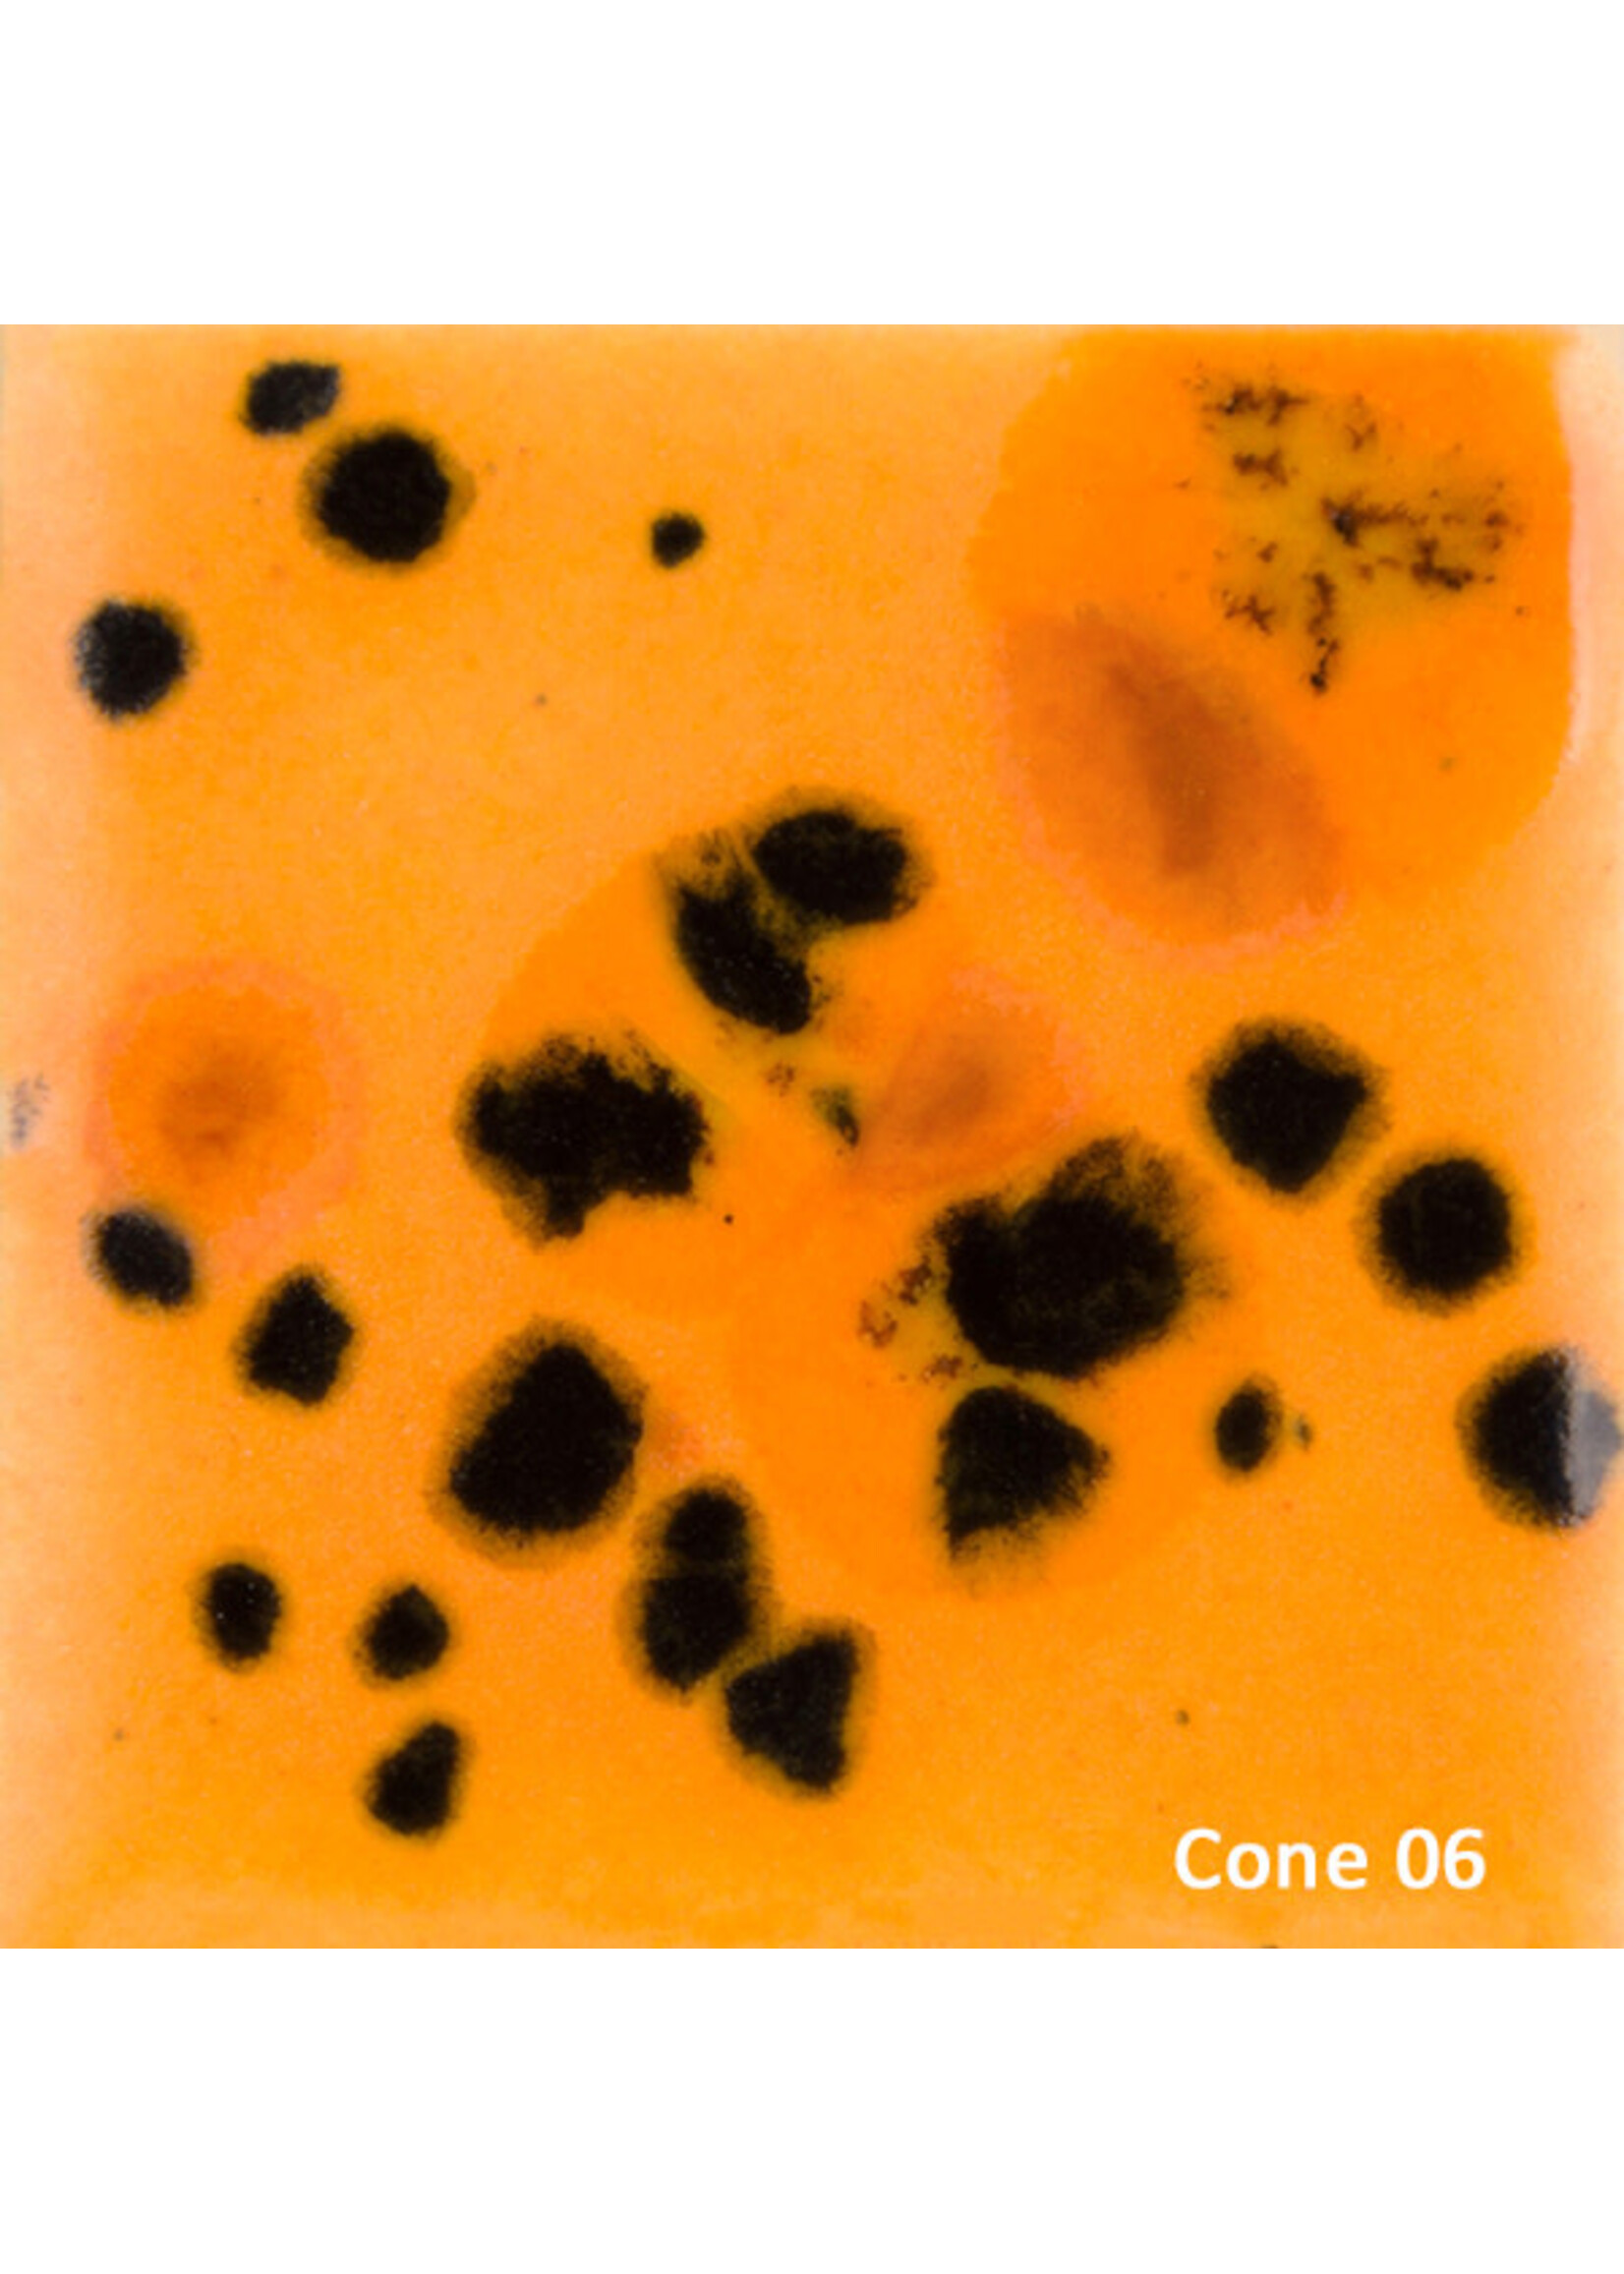

Large selection of products and fast shipping!
- Clay*
- Glaze & Colour*
- Raw materials*
- Wheels*
- Books*
- T-shirts*
- Sanbao Decals
- Brushes*
-
Tools*
- All Tools*
- Calipers
- Loop Tools
- Sponges
- Ribs
- Pattern & Texture Tools
- cutting wires
- Knives and pins
- Turning tools
- Handle cutters
- Kidneys
- throwing sticks
- Coilers
- Slip trailers & bottles
- Hole cutters
- Tile cutters
- Modelling tools
- tongs
- clay guns
- Glaze pipes
- Sieves
- Tool sets
- Rolling pins and guides
- Throwing Aids
- Plaster*
- Firing Accessories*
- Glaze Stains*
- Buckets*
- Kilns*
- Refractories*
- Slabrollers*
- Accessories*
- Whirlers*
- Gift cards (physical)
- Pugmills*
- Cones*
- Equipment*
- Kiln Furniture*
- Throwing Batts*
- Mudtools*
- Xiem Tools
- Diamondcore Tools*
- MKM Stamps & Rollers*
- Workshops
- CLEARANCE!
- Gift cards
- E-Gift Cards